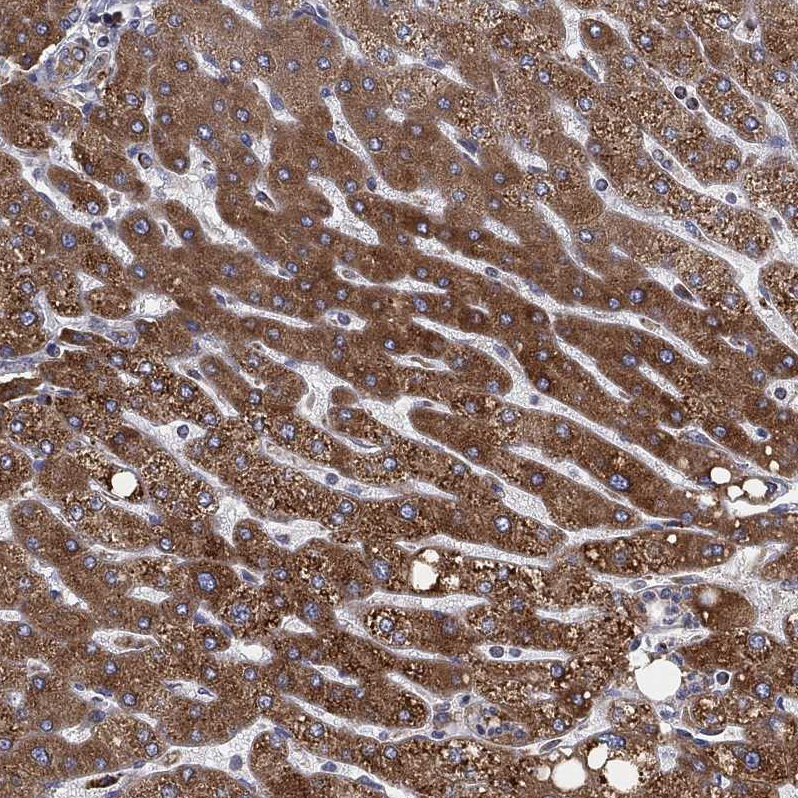

All products are designed for the highest possible performance and are manufactured using a standardized process to ensure the most rigorous levels of quality.
The Anti‑CYB5B antibody (HPA007893) is a specific research tool designed to detect CYB5B (Cytochrome b5 type B), a membrane/intracellular protein with broad cellular presence and a defined subcellular localization profile.
According to the Human Protein Atlas, CYB5B shows a tissue‑enhanced RNA expression pattern in adrenal gland, clustering with genes associated with “Adrenal gland – Steroid metabolism (mainly)”, highlighting its relevance for studies connected to steroidogenic tissue biology and metabolism‑linked cellular pathways.
Significance in Research: HPA data indicate CYB5B has general cytoplasmic expression at the protein level across tissues, supporting its usefulness as a marker/target in studies where broad cellular expression is expected rather than strict tissue restriction. Importantly, HPA subcellular mapping localizes CYB5B primarily to the endoplasmic reticulum (ER) (approved main location), with additional localization reported in the cytosol and centriolar satellite, making it relevant for investigations of ER‑associated cellular processes and compartment‑specific protein biology. HPA also classifies CYB5B under “Plasma proteins” and provides evidence at protein level, indicating the target is supported by experimental protein evidence in their resource framework.
Corresponding antigens
With Atlas Antibodies you get

From our facilities in Stockholm, Sweden we develop, manufacture and distribute highly advanced reagents to the Life Sciences community worldwide.

Our products are available to customers worldwide. From most locations, you can order our products from Atlas Antibodies. Please see more information about how to order here.

Learn how we validate our antibodies, how we secure their reproducibility, and why we apply enhanced validation. Our antibodies are validated in IHC, ICC-IF, and WB.